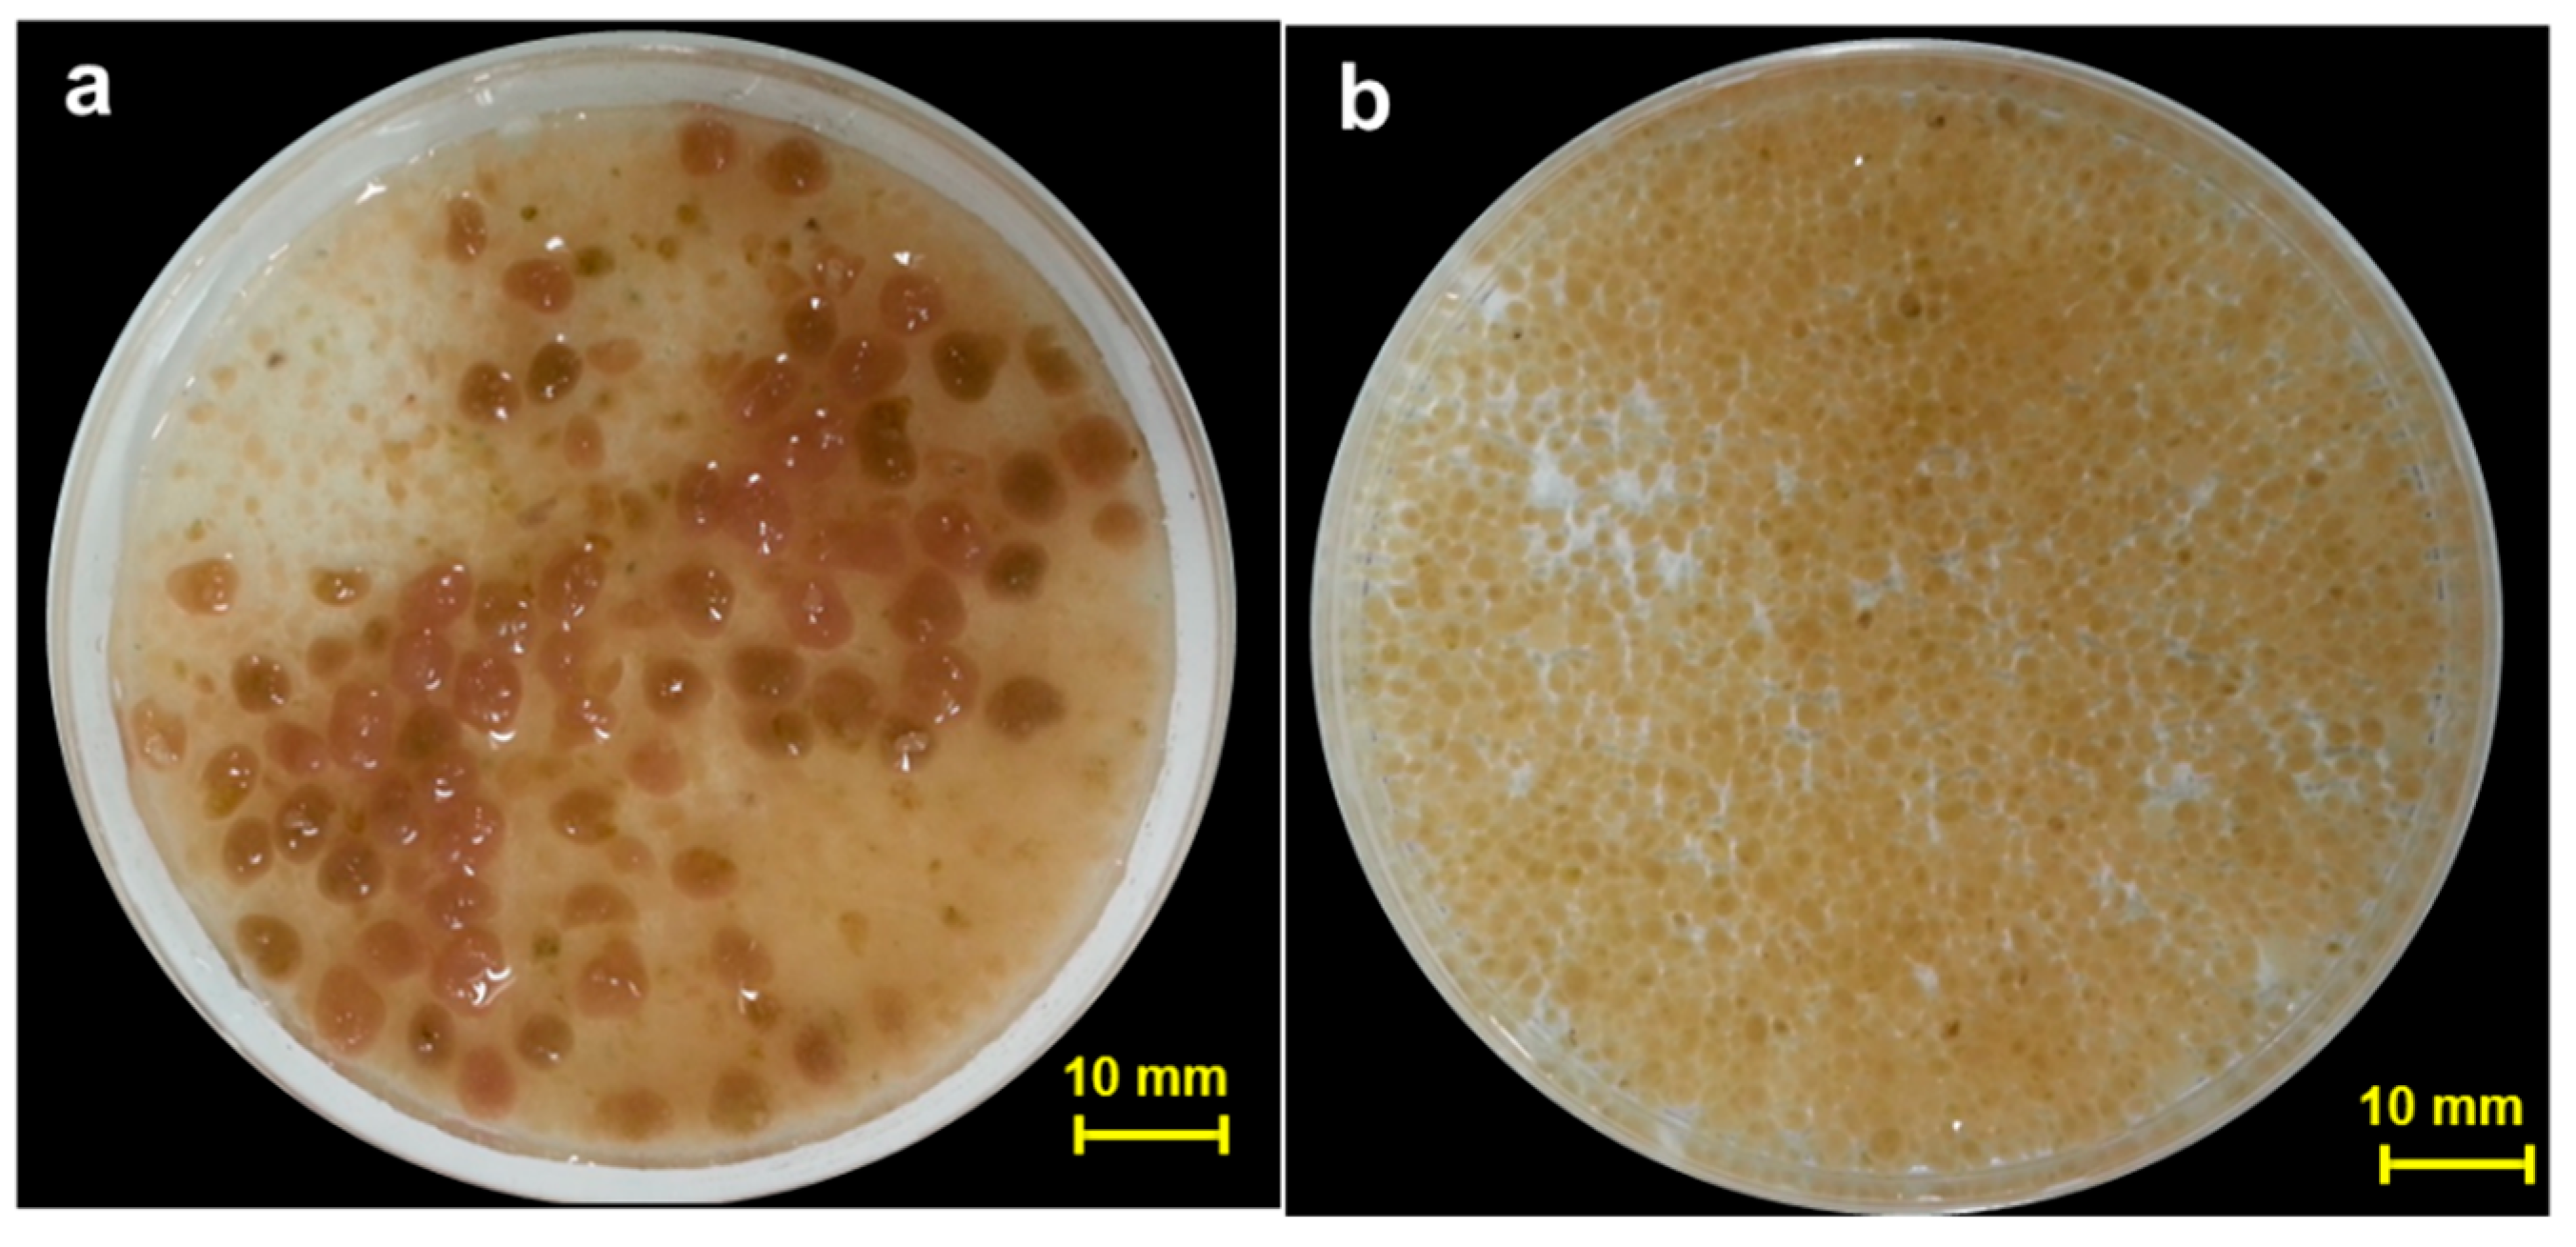
Water 15 04108 g001

Factors Affecting the Morphology of Granular Sludge in Phosphorus-Accumulating Organism (PAO) and Denitrifying PAO (DPAO) Sequencing Batch Reactors
Abstract
1. Introduction
2. Materials and Methods
2.1. Reactor Configuration and Operational Conditions
2.2. Synthetic Wastewater
2.3. Data Analysis
2.4. Analytical Methods
3. Results and Discussion
3.1. Morphological Characteristics of Granules
3.2. Effect of PH on HAP Precipitation
3.3. Possible Factors Influencing Granule Formation
3.4. Granulation and EA
4. Conclusions
Supplementary Materials
Author Contributions
Funding
Data Availability Statement
Conflicts of Interest
References
- Ministry of the Environment (MOE) in Korea. Enforcement Regulations of Sewerage and Drainage Law. Available online: https://elaw.klri.re.kr/eng_mobile/newLawViewer.do?hseq=62188&type=tot&key=%ED%95%98%EC%88%98%EB%8F%84%EB%B2%95%20%EC%8B%9C%ED%96%89%EB%A0%B9&pCode=&pName= (accessed on 22 October 2023).
- Kerrn-Jespersen, J.P.; Henze, M. Biological phosphorus uptake under anoxic and aerobic conditions. Water Res. 1993, 27, 617–624. [Google Scholar] [CrossRef]
- Morgenroth, E.; Sherden, T.; van Loosdrecht, M.C.M.; Heijnen, J.J.; Wilderer, P.A. Aerobic granular sludge in a sequencing batch reactor. Water Res. 1997, 31, 3191–3194. [Google Scholar] [CrossRef]
- Beun, J.J.; Hendriks, A.; van Loosdrecht, M.C.M.; Morgenroth, E.; Wilderer, P.A.; Heijnen, J.J. Aerobic granulation in a sequencing batch reactor. Water Res. 1999, 33, 2283–2290. [Google Scholar] [CrossRef]
- Tay, J.H.; Liu, Q.S.; Liu, Y. Microscopic observation of aerobic granulation in sequential aerobic sludge blanket reactor. J. Appl. Microbiol. 2001, 91, 168–175. [Google Scholar] [CrossRef] [PubMed]
- Yang, S.F.; Tay, J.H.; Liu, Y. Inhibition of free ammonia to the formation of aerobic granules. Biochem. Eng. J. 2004, 17, 41–48. [Google Scholar] [CrossRef]
- Liu, Y.; Tay, J.H. State of the art of biogranulation technology for wastewater treatment. Biotechnol. Adv. 2004, 22, 533–563. [Google Scholar] [CrossRef]
- Adav, S.S.; Lee, D.J.; Lai, J.Y. Effects of aeration intensity on formation of phenol-fed aerobic granules and extracellular polymeric substances. Appl. Microbiol. Biotechnol. 2007, 77, 175–182. [Google Scholar] [CrossRef]
- Coma, M.; Puig, S.; Balaguer, M.D.; Colprim, J. The role of nitrate and nitrite in a granular sludge process treating low-strength wastewater. Chem. Eng. J. 2010, 164, 208–213. [Google Scholar] [CrossRef]
- Lochmatter, S.; Maillard, J.; Holliger, C. Nitrogen removal over nitrite by aeration control in aerobic granular sludge sequencing batch reactors. Int. J. Environ. Res. Public Health 2014, 11, 6955–6978. [Google Scholar] [CrossRef]
- Zhang, H.; Dong, F.; Jiang, T.; Wei, Y.; Wang, T.; Yang, F. Aerobic granulation with low strength wastewater at low aeration rate in A/O/A SBR reactor. Enzym. Microb. Technol. 2011, 49, 215–222. [Google Scholar] [CrossRef]
- Wu, C.Y.; Peng, Y.Z.; Wang, S.Y.; Ma, Y. Enhanced biological phosphorus removal by granular sludge: From macro- to micro-scale. Water Res. 2010, 44, 807–814. [Google Scholar] [CrossRef] [PubMed]
- Angela, M.; Béatrice, B.; Mathieu, S. Biologically induced phosphorus precipitation in aerobic granular sludge process. Water Res. 2011, 45, 3776–3786. [Google Scholar] [PubMed]
- He, Q.; Zhang, W.; Zhang, S.; Wang, H. Enhanced nitrogen removal in an aerobic granular sequencing batch reactor performing simultaneous nitrification, endogenous denitrification and phosphorus removal with low superficial gas velocity. Chem. Eng. J. 2017, 326, 1223–1231. [Google Scholar] [CrossRef]
- Yilmaz, G.; Lemaire, R.; Keller, J.; Yuan, Z.G. Simultaneous nitrification, denitrification, and phosphorus removal from nutrient-rich industrial wastewater using granular sludge. Biotechnol. Bioeng. 2008, 100, 529–541. [Google Scholar] [CrossRef] [PubMed]
- Meinhold, J.; Arnold, E.; Isaacs, S. Effect of nitrite on anoxic phosphate uptake in biological phosphorus removal activated sludge. Water Res. 1999, 33, 1871–1883. [Google Scholar] [CrossRef]
- Lee, H.; Yun, Z. Comparison of biochemical characteristics between PAO and DPAO sludges. J. Environ. Sci. 2014, 26, 1340–1347. [Google Scholar] [CrossRef]
- Yun, G.; Lee, H.; Hong, Y.; Kim, S.; Daigger, G.T.; Yun, Z. The difference of morphological characteristics and population structure in PAO and DPAOgranular sludges. J. Environ. Sci. 2019, 76, 388–402. [Google Scholar] [CrossRef]
- Guo, Y.; Chen, Y.; Webeck, E.; Li, Y.-Y. Towards more efficient nitrogen removal and phosphorus recovery from digestion effluent: Latest developments in the anammox-based process from the application perspective. Bioresour. Technol. 2020, 299, 122560. [Google Scholar] [CrossRef]
- Xue, Y.; Ma, H.; Kong, Z.; Guo, Y.; Li, Y.-Y. Bulking and floatation of the anammox-HAP granule caused by low phosphate concentration in the anammox reactor of expanded granular sludge bed (EGSB). Bioresour. Technol. 2020, 310, 123421. [Google Scholar] [CrossRef]
- Guo, Y.; Li, Y.-Y. Hydroxyapatite crystallization-based phosphorus recovery coupling with the nitrogen removal through partial nitritation/anammox in a single reactor. Water Res. 2020, 187, 116444. [Google Scholar] [CrossRef]
- Xue, Y.; Ma, H.; Kong, Z.; Li, Y.-Y. Formation Mechanism of hydroxyapatite encapsulation in Anammox-HAP Coupled Granular Sludge. Water Res. 2021, 193, 116861. [Google Scholar] [CrossRef] [PubMed]
- Kong, Y.H.; Liu, Y.Q.; Tay, J.H.; Wong, F.S.; Zhu, J.R. Aerobic granulation in sequencing batch reactors with different reactor height/diameter ratios. Enzyme Microb. Technol. 2009, 45, 379–383. [Google Scholar] [CrossRef]
- Liu, Y.; Tay, J.H. The essential role of hydrodynamic shear force in the formation of biofilm and granular sludge. Water Res. 2002, 36, 1653–1665. [Google Scholar] [CrossRef] [PubMed]
- Dulekgurgen, E.; Artan, N.; Orhon, D.; Wilderer, P.A. How does shear affect aggregation in granular sludge sequencing batch reactors? Relations between shear, hydrophobicity, and extracellular polymeric substances. Water Sci. Technol. 2008, 58, 267–276. [Google Scholar] [CrossRef] [PubMed][Green Version]
- Liu, Y.Q.; Tay, J.H. Influence of starvation time on formation and stability of aerobic granules in sequencing batch reactors. Bioresour. Technol. 2008, 99, 980–985. [Google Scholar] [CrossRef] [PubMed]
- McSwain, B.S.; Irvine, R.L.; Hausner, M.; Wilderer, P.A. Composition and distribution of extracellular polymeric substances in aerobic flocs and granular sludge. Appl. Environ. Microbiol. 2005, 71, 1051–1057. [Google Scholar] [CrossRef] [PubMed]
- Lopez-Vazquez, C.M.; Oehmen, A.; Hooijmans, C.M.; Brdjanovic, D.; Gijzen, H.J.; Yuan, Z.; van Loosdrecht, M.C. Modeling the PAO–GAO competition: Effects of carbon source, pH and temperature. Water Res. 2009, 43, 450–462. [Google Scholar] [CrossRef] [PubMed]
- Oehmen, A.; Lopez-Vazquez, C.M.; Carvalho, G.; Reis, M.A.M.; Van Loosdrecht, M.C.M. Modelling the population dynamics and metabolic diversity of organisms relevant in anaerobic/anoxic/aerobic enhanced biological phosphorus removal processes. Water Res. 2010, 44, 4473–4486. [Google Scholar] [CrossRef]
- Weng, C.N.; Molof, A.H. Nitrification in the biological fixed-film rotating disk system. Water Pollut. Control. Fed. 1974, 46, 1674–1685. [Google Scholar]
- Frølund, B.; Palmgren, R.; Keiding, K.; Nielsen, P.H. Extraction of extracellular polymers from activated sludge using a cation exchange resin. Water Res. 1996, 30, 1749–1758. [Google Scholar] [CrossRef]
- Lowry, O.H.; Rosebrough, N.J.; Farr, A.L.; Randall, R.J. Protein measurement with the Folin phenol reagent. J. Biol. Chem. 1951, 193, 265–275. [Google Scholar] [CrossRef] [PubMed]
- Zhang, B.; Ji, M.; Qiu, Z.; Liu, H.; Wang, J.; Li, J. Microbial population dynamics during sludge granulation in an anaerobic–aerobic biological phosphorus removal system. Bioresour. Technol. 2011, 102, 2474–2480. [Google Scholar] [CrossRef] [PubMed]
- de Kreuk, M.K.; van Loosdrecht, M.C. Formation of aerobic granules with domestic sewage. J. Environ. Eng. 2006, 132, 694–697. [Google Scholar] [CrossRef]
- Saidou, H.; Korchef, A.; Ben Moussa, S.; Ben Amor, M. Struvite precipitation by the dissolved CO2 degasification technique: Impact of the airflow rate and pH. Chemosphere 2009, 74, 338–343. [Google Scholar] [CrossRef] [PubMed]
- Zhu, G.B.; Peng, Y.Z.; Wu, S.Y.; Wang, S.Y.; Xu, S.W. Simultaneous nitrification and denitrification in step feeding biological nitrogen removal process. J. Environ. Sci. 2007, 19, 1043–1048. [Google Scholar] [CrossRef] [PubMed]
- Dsane, V.F.; Jeon, H.; Choi, Y.; Jeong, S.; Choi, Y. Characterization of magnetite assisted anammox granules based on in-depth analysis of extracellular polymeric substance (EPS). Bioresour. Technol. 2023, 369, 128372. [Google Scholar] [CrossRef] [PubMed]
- Lv, L.; Feng, C.; Li, W.; Ren, Z.; Wang, P.; Liu, X.; Gao, W.; Sun, L.; Zhang, G. Accelerated performance recovery of anaerobic granular sludge after temperature shock: Rapid construction of protective barriers (EPS) to optimize microbial community composition base on quorum sensing. J. Clean. Prod. 2023, 392, 136243. [Google Scholar] [CrossRef]
- Samaei, S.H.A.; Chen, J.; Xue, J. Current progress of continuous-flow aerobic granular sludge: A critical review. Sci. Total Environ. 2023, 875, 162633. [Google Scholar] [CrossRef]
- Chuprunov, K.; Yudin, A.; Lysov, D.; Kolesnikov, E.; Kuznetsov, D.; Leybo, D.; Ilinykh, I.; Godymchuk, A. The pH level influence on hydroxyapatite phase composition synthesized with hydrothermal method. In IOP Conference Series: Materials Science and Engineering, Proceedings of the International Science and Technology Conference for Youth "Advanced Materials for Engineering and Medicine", Tomsk, Russian, 30 September–5 October 2019; IOP Publishing: Bristol, UK, 2020; Volume 731, p. 012023. [Google Scholar]
- López-Ortiz, S.; Mendoza-Anaya, D.; Sánchez-Campos, D.; Fernandez-García, M.E.; Salinas-Rodríguez, E.; Reyes-Valderrama, M.I.; Rodríguez-Lugo, V. The pH effect on the growth of hexagonal and monoclinic hydroxyapatite synthesized by the hydrothermal method. J. Nanomater. 2020, 2020, 5912592. [Google Scholar] [CrossRef]
- Jorand, F.; Boué-Bigne, F.; Block, J.C.; Urbain, V. Hydrophobic/hydrophilic properties of activated sludge exopolymeric substances. Water Sci. Technol. 1998, 37, 307–315. [Google Scholar] [CrossRef]
- Li, X.M.; Liu, Q.Q.; Yang, Q.; Guo, L.; Zeng, G.M.; Hu, J.M.; Zheng, W. Enhanced aerobic sludge granulation in sequencing batch reactor by Mg2+ augmentation. Bioresour. Technol. 2009, 100, 64–67. [Google Scholar] [CrossRef] [PubMed]
- Muda, K.; Aris, A.; Salim, M.R.; Ibrahim, Z.; van Loosdrecht, M.C.M.; Ahmad, A.; Nawahwi, M.Z. The effect of hydraulic retention time on granular sludge biomass in treating textile wastewater. Water Res. 2011, 45, 4711–4721. [Google Scholar] [CrossRef] [PubMed]
- Owusu-Agyeman, I.; Eyice, Ö.; Cetecioglu, Z.; Plaza, E. The study of structure of anaerobic granules and methane producing pathways of pilot-scale UASB reactors treating municipal wastewater under sub-mesophilic conditions. Bioresour. Technol. 2019, 290, 121733. [Google Scholar] [CrossRef] [PubMed]
- Kim, J.; Park, J.; Choi, H.; Lee, C. Performance and stability enhancement of methanogenic granular sludge process: Feed pre-acidification and magnetite-embedded granule formation. Chem. Eng. J. 2023, 469, 143864. [Google Scholar] [CrossRef]
- Quoc, B.N.; Wei, S.; Armenta, M.; Bucher, R.; Sukapanpotharam, P.; Stahl, D.A.; Stensel, H.D.; Winkler, M.-K.H. Aerobic granular sludge: Impact of size distribution on nitrification capacity. Water Res. 2021, 188, 116445. [Google Scholar] [CrossRef]
- van den Berg, L.; Pronk, M.; van Loosdrecht, M.C.; de Kreuk, M. Density measurements of aerobic granular sludge. Environ. Technol. 2023, 44, 1985–1995. [Google Scholar] [CrossRef]
- Wang, D.; Fu, Q.; Xu, Q.; Liu, Y.; Ngo, H.H.; Yang, Q.; Zeng, G.; Li, X.; Ni, B.-J. Free nitrous acid-based nitrifying sludge treatment in a two-sludge system enhances nutrient removal from low carbon wastewater. Bioresour. Technol. 2017, 244, 920–928. [Google Scholar] [CrossRef]

| Factors | An–Ox SBR (PAO) | An–Ax SBR (DPAO) | Difference | ||
|---|---|---|---|---|---|
| Reactor operating condition | OLR (kg/m3·d) | 0.49 | 0.49 | ||
| Aver. SRT (day) | 34.56 | 40.02 | × | ||
| HRT (h) | 13.9 | 13.9 | |||
| Reactor vol. (L) | 5.9 | 5.9 | |||
| H/D ratio | 1.9 | 1.9 | |||
| Settling time (min) | 30 | 30 | |||
| C/N ratio | 8.3 | 8.3 | |||
| F/M ratio | 0.12 | 0.12 | |||
| MLSS (mg/L) | 2812 | 2226 | |||
| Aeration intensity (cm/s) | 1.46 | - | |||
| Aver. pH | An | 7.28 | 7.34 | × | |
| Ox | 6.78 | - | × | ||
| Ax | - | 8.85 | × | ||
| DO (mg/L) | 3 | 0.04 | × | ||
| Type of electron acceptor | Molecular O2 | Bounded O2 (NO3) | × | ||
| Granule characteristics | Core Aver. diameter (mm) | No | Yes | × | |
| 0.41 | 2.20 | × | |||
| SVI30 (mL/g) | 84 | 97 | |||
| Aver. EPS conc. (mg/g vss) | 23.93 | 36.07 | × | ||
| Operating Parameters | Variable Number (n) | Pearson Correlation (p) |
|---|---|---|
| H/D ratio | 56 | −0.292 * |
| OLR (kg/m3·d) | 42 | −037 |
| SVI (mL/g) | 48 | 0.047 |
| MLSS (mg/L) | 32 | 0.172 |
| SRT (d) | 24 | 0.160 |
| HRT (h) | 46 | −0.160 |
| Settling time (min) | 58 | −0.203 |
| Aeration intensity (cm/s) | 47 | −250 |
| F/M ratio | 28 | 0.208 |
| Avg. EPS conc. (mg/g vss) | 21 | −0.012 |
Disclaimer/Publisher’s Note: The statements, opinions and data contained in all publications are solely those of the individual author(s) and contributor(s) and not of MDPI and/or the editor(s). MDPI and/or the editor(s) disclaim responsibility for any injury to people or property resulting from any ideas, methods, instructions or products referred to in the content. |
© 2023 by the authors. Licensee MDPI, Basel, Switzerland. This article is an open access article distributed under the terms and conditions of the Creative Commons Attribution (CC BY) license (https://creativecommons.org/licenses/by/4.0/).
Share and Cite
Yun, G.; Yun, Z.; Kim, Y.; Han, K. Factors Affecting the Morphology of Granular Sludge in Phosphorus-Accumulating Organism (PAO) and Denitrifying PAO (DPAO) Sequencing Batch Reactors. Water 2023, 15, 4108. https://doi.org/10.3390/w15234108
Yun G, Yun Z, Kim Y, Han K. Factors Affecting the Morphology of Granular Sludge in Phosphorus-Accumulating Organism (PAO) and Denitrifying PAO (DPAO) Sequencing Batch Reactors. Water. 2023; 15(23):4108. https://doi.org/10.3390/w15234108
Chicago/Turabian StyleYun, Geumhee, Zuwhan Yun, Young Kim, and Kyungjin Han. 2023. "Factors Affecting the Morphology of Granular Sludge in Phosphorus-Accumulating Organism (PAO) and Denitrifying PAO (DPAO) Sequencing Batch Reactors" Water 15, no. 23: 4108. https://doi.org/10.3390/w15234108
APA StyleYun, G., Yun, Z., Kim, Y., & Han, K. (2023). Factors Affecting the Morphology of Granular Sludge in Phosphorus-Accumulating Organism (PAO) and Denitrifying PAO (DPAO) Sequencing Batch Reactors. Water, 15(23), 4108. https://doi.org/10.3390/w15234108








